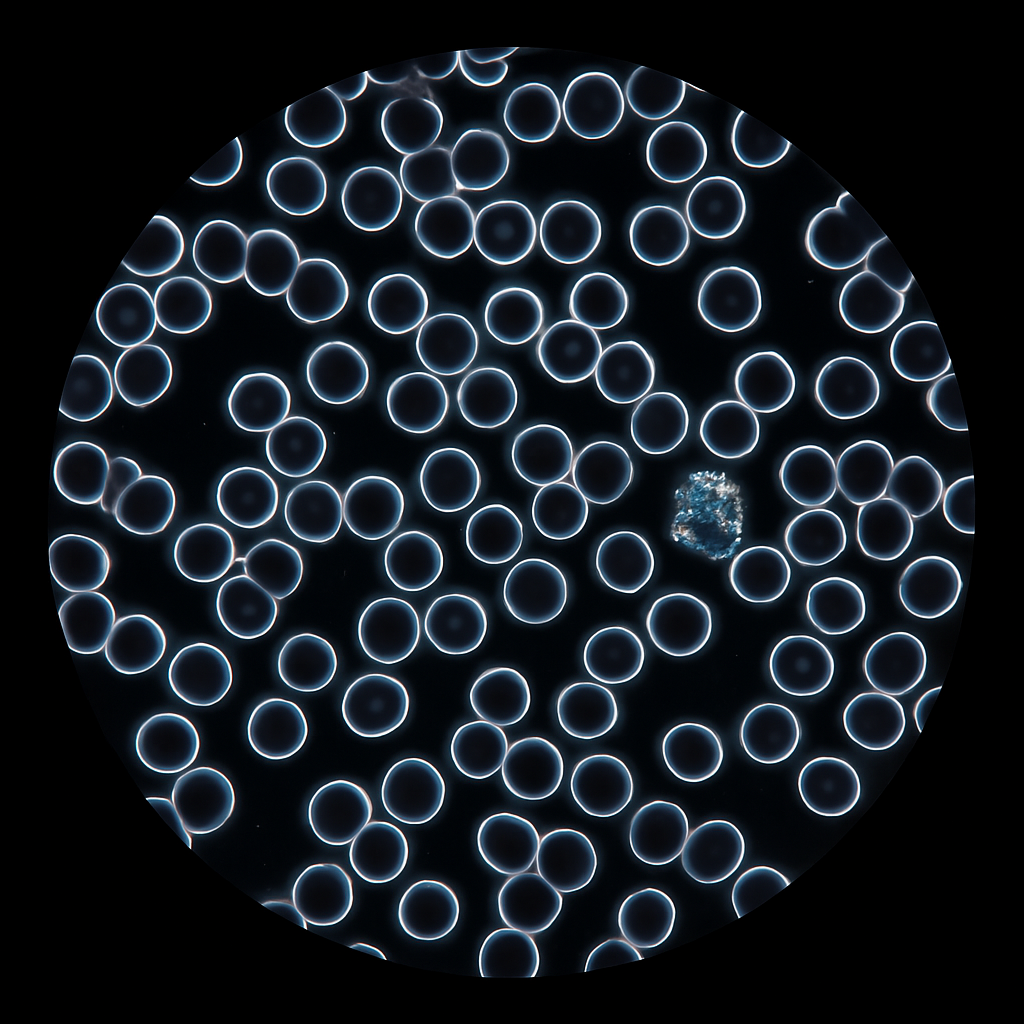

Allura Health & Wellness
Integrative Wellness Therapies
Integrative Wellness Therapies
🌿 Integrative Wellness Therapies
Discover a holistic approach to health and well-being with our Integrative Wellness Therapies. Blending cutting-edge diagnostics with natural, non-invasive treatments, we help you restore balance, enhance vitality, and support your physical, emotional, and mental health.
Each therapy is designed to promote detoxification, boost immune function, and optimize your body’s natural healing capacity.
🧬 Key Therapies Offered
- Hydrotherapy with Hydrogen (1 hour): Support cellular health and deep detoxification using high-purity molecular hydrogen.
- Ozone Therapy (30 min): Improve oxygenation and stimulate immune function with this powerful, revitalizing treatment.
- Meta Hunter Biofeedback (1 hour): A non-invasive scan that detects energetic imbalances and helps guide personalized wellness strategies.
- Dark Field Blood Examination (30 min): A live blood analysis to evaluate internal health, oxidative stress, and immune function in real time.
- Body Scan Solar Evaluation (30 min): Understand your body’s energetic zones with this fast, informative diagnostic scan.
- Integrative Health Consultation: A full assessment with our integrative team to map out your personalized wellness plan.
- Allura Health Check-Up: A general wellness evaluation to monitor and maintain your body’s health baseline.
💡 We are constantly expanding our therapies to align with your wellness journey. Experience personalized care that connects body, mind, and spirit — all in one place.
💙 We Honor Our Community
Military, First Responders, Students, and Teachers verified through
ID.me will receive their discount
in-store at Allura Health & Wellness after booking.
Share